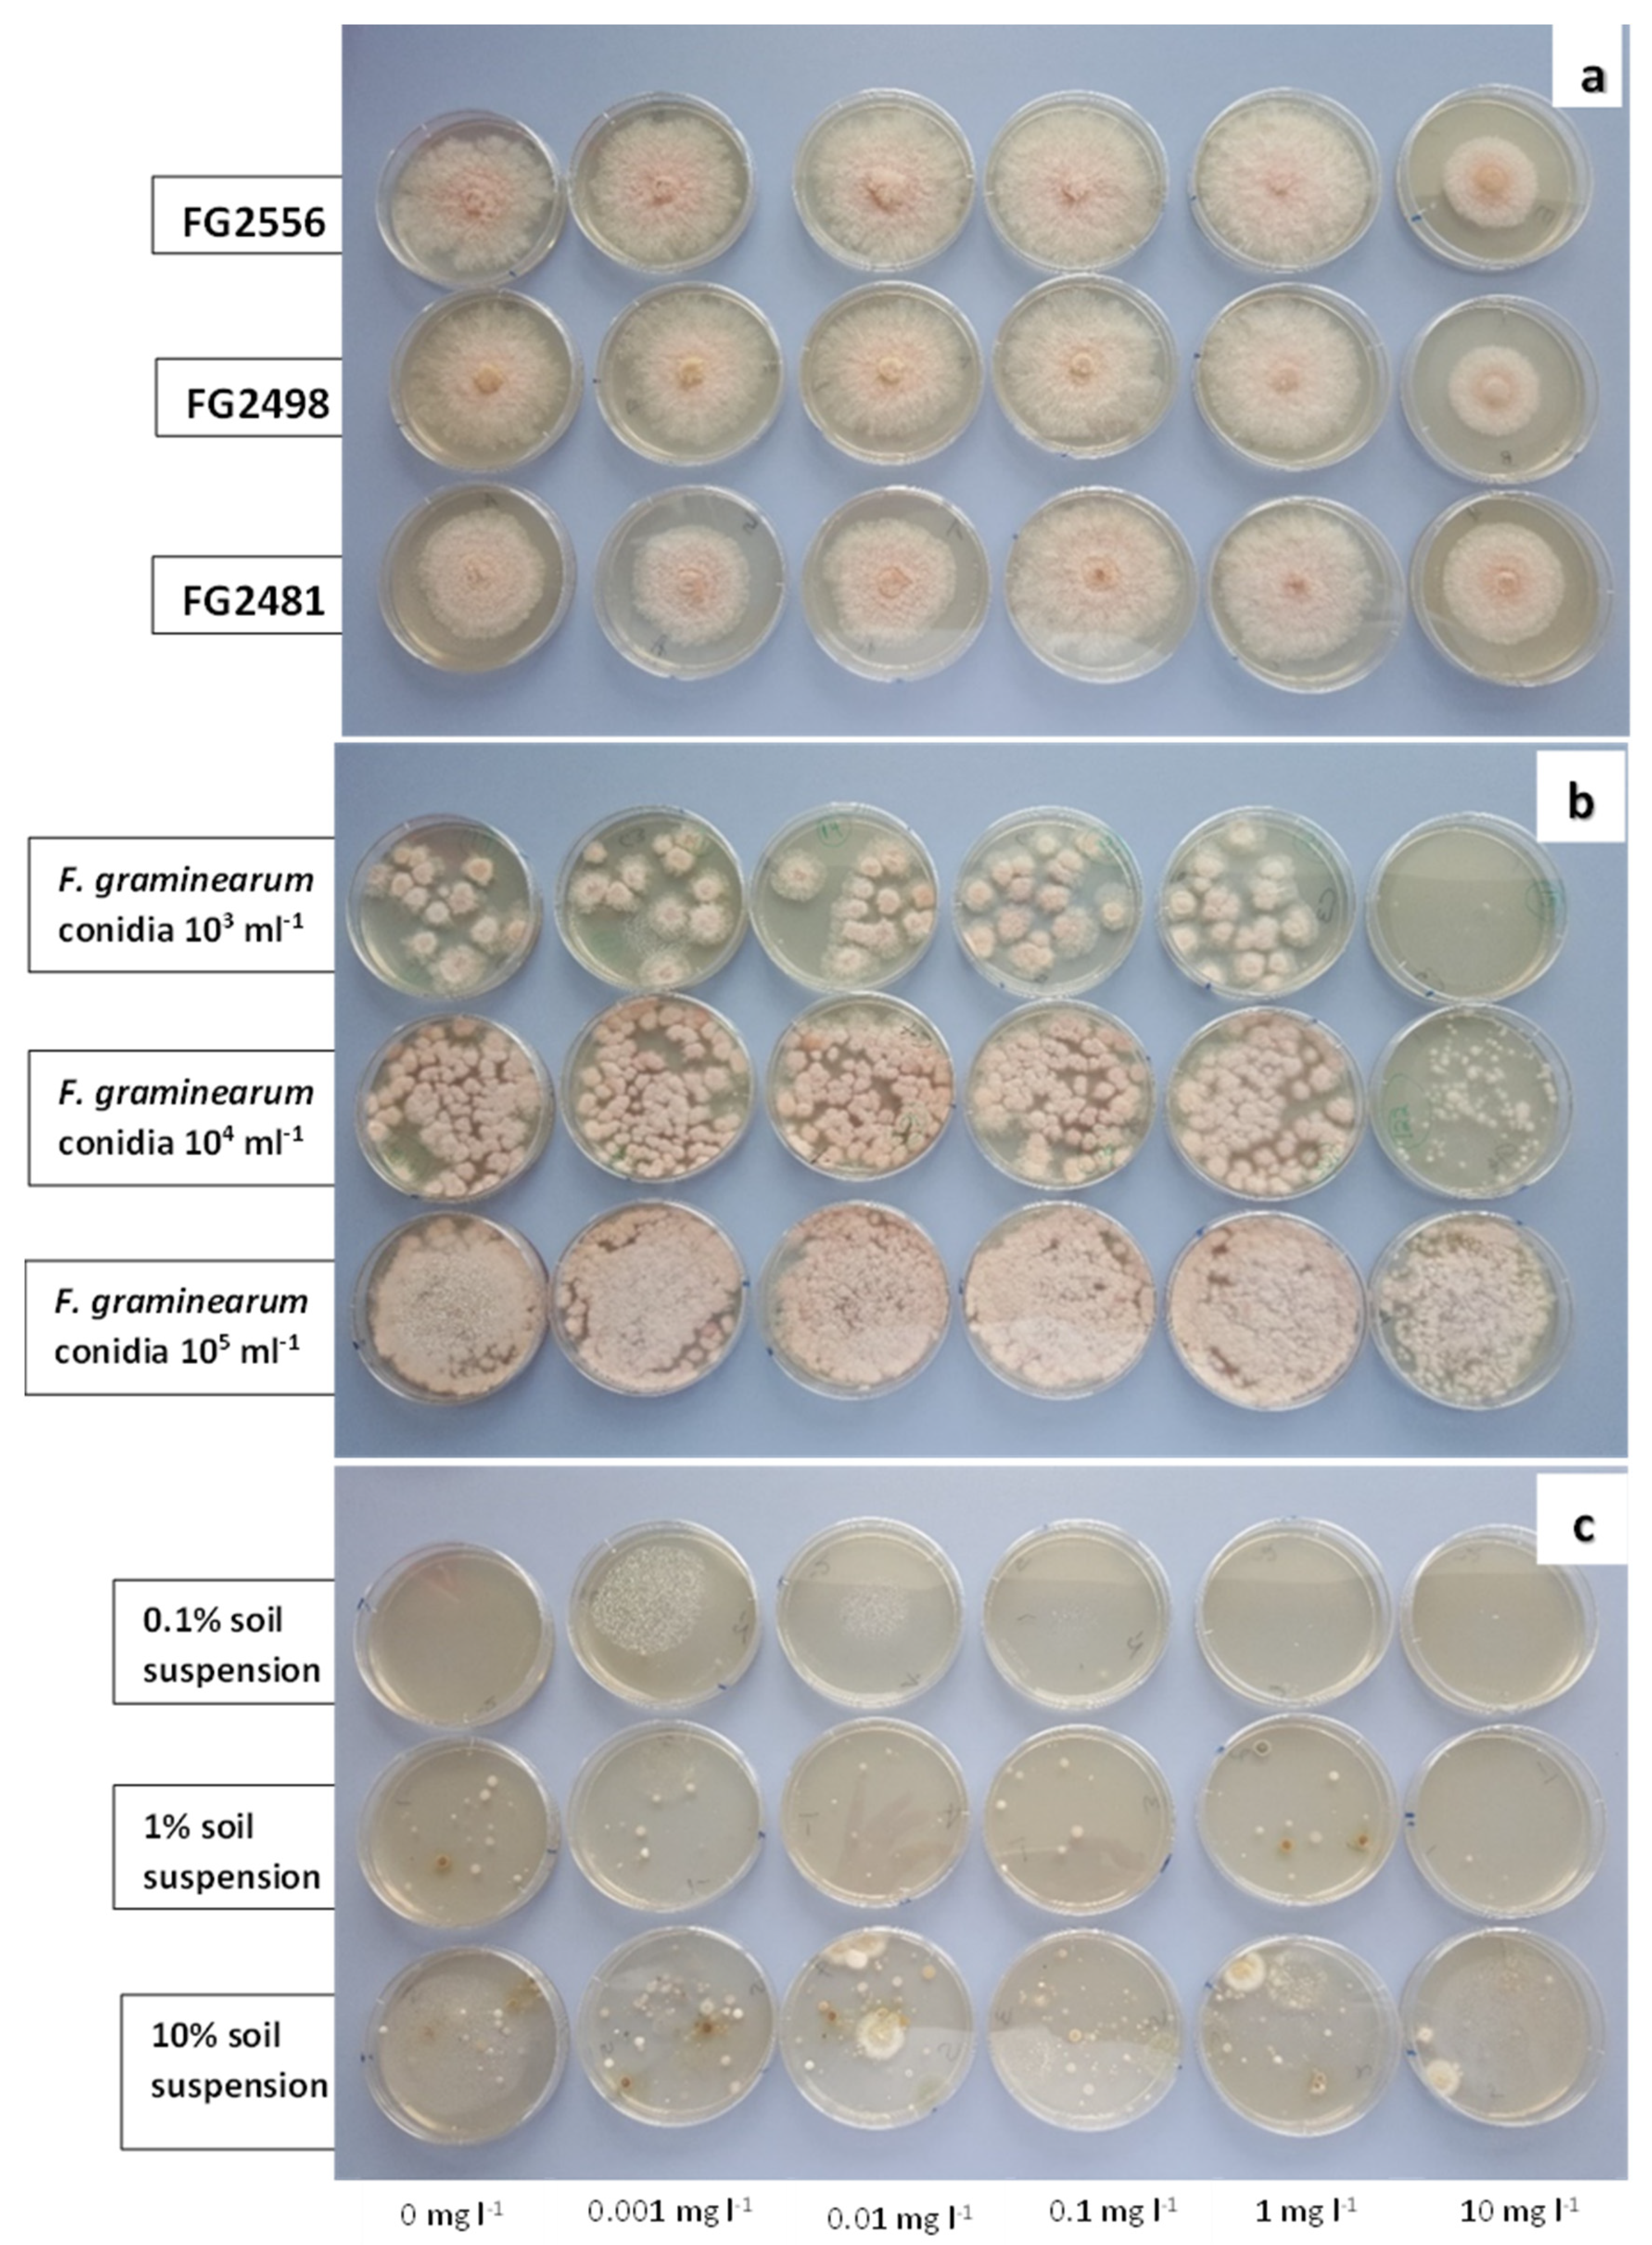
Pathogens 12 00197 g002 Pathogens 12 00197 g002
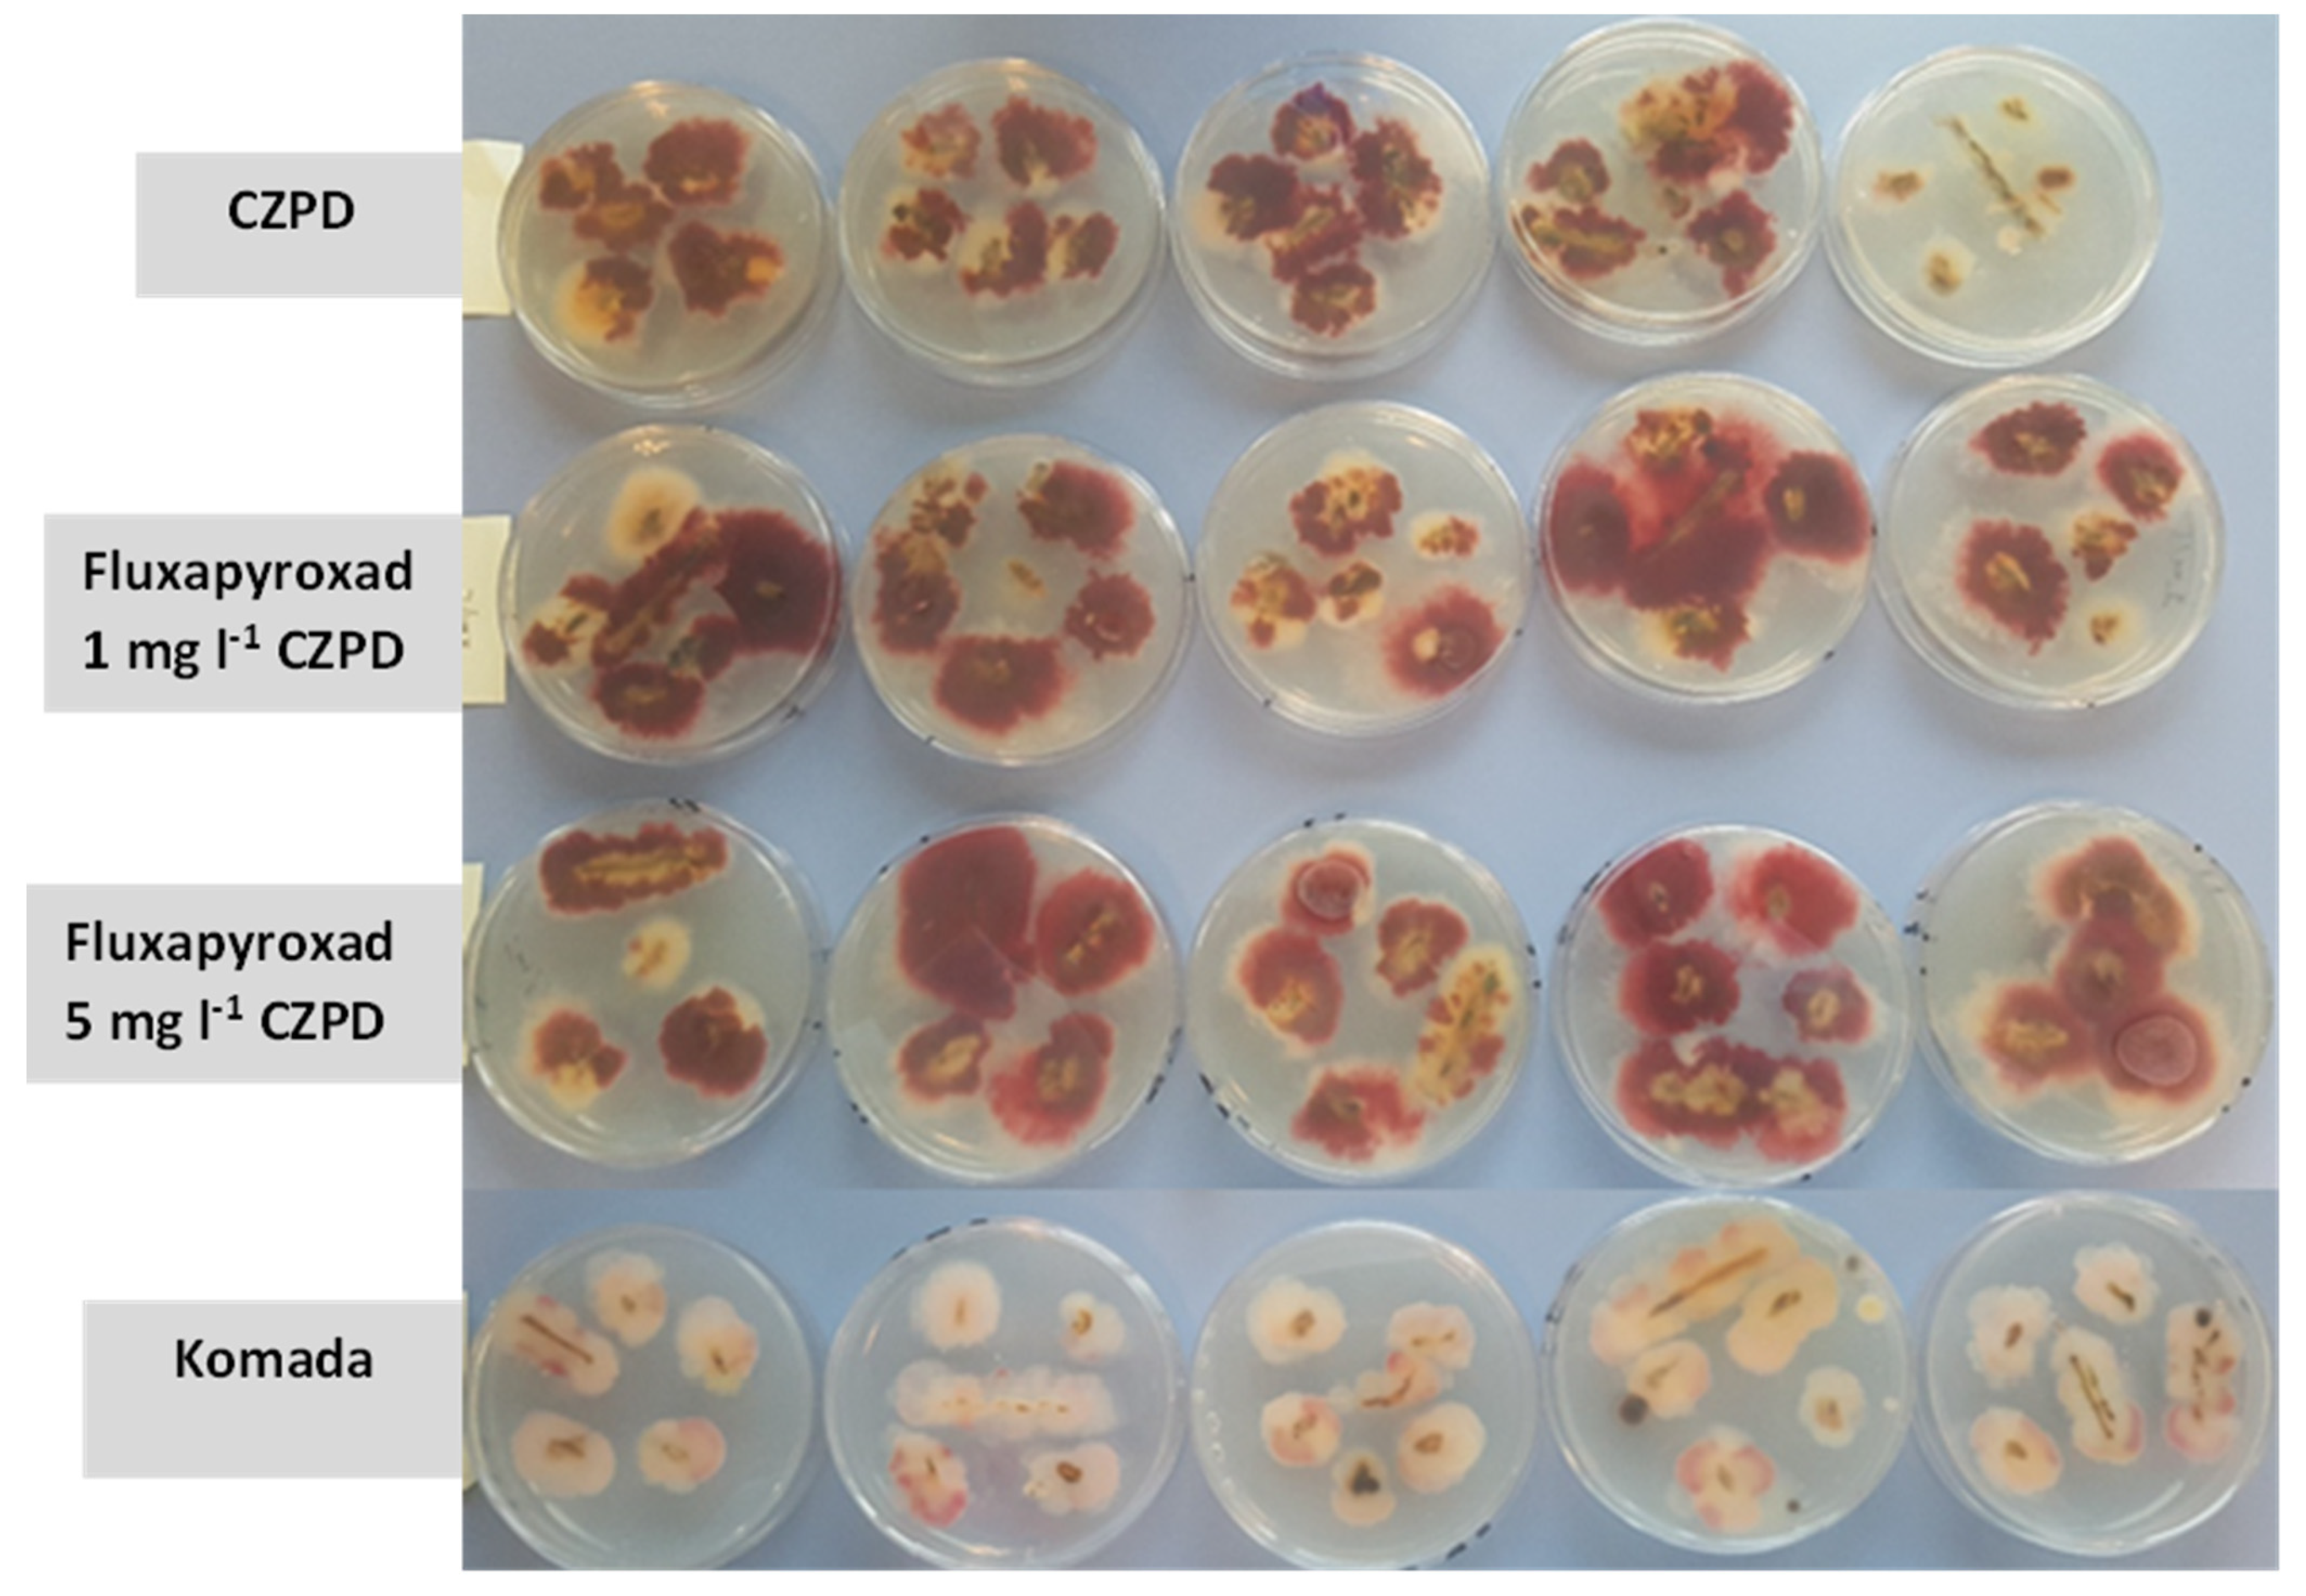
Pathogens 12 00197 g003 Pathogens 12 00197 g003

Screening of Fungicides and Comparison of Selective Media for Isolation of Fusarium graminearum from Soil and Plant Material
Abstract
1. Introduction
2. Materials and Methods
2.1. Fusarium graminearum Strains
2.2. Czapek Dox Propiconazole Dichloran Agar
2.3. Preliminary Screening of Fungicides
2.4. Isolation of Fusarium graminearum from Soil Using CZPD with and without Fluxapyroxad
2.5. Comparing Selectivity of Media Using Fusarium graminearum-Infected Wheat Debris
3. Results
3.1. Isolation of Fusarium graminearum from Soil Using Fluxapyroxad
3.2. Selectivity of Media for Isolation of Fusarium graminearum from Wheat Debris
4. Discussion
Author Contributions
Funding
Institutional Review Board Statement
Informed Consent Statement
Data Availability Statement
Acknowledgments
Conflicts of Interest
References
- Nash, S.M.; Snyder, W.C. Quantitative estimations by plate counts of propagules of the bean root rot Fusarium in field soils. Phytopathology 1962, 52, 567–572. [Google Scholar]
- Papavizas, G.C. Evaluation of various media and anti-microbial agents for isolation of Fusarium from soil. Phytopathology 1967, 57, 848–852. [Google Scholar]
- Komada, H. Development of a selective medium for quantitative isolation of Fusarium oxysporum from natural soil. Rev. Plant Prot. Res. 1975, 8, 114–124. [Google Scholar]
- Van Wyk, P.S.; Scholtz, D.J.; Los, O. A selective medium for the isolation of Fusarium spp. from soil debris. Phytophylactica 1986, 18, 67–70. [Google Scholar]
- Andrews, S.; Pitt, J.I. Selective medium for isolation of Fusarium species and dematiaceous hyphomycetes from cereals. Appl. Environ. Microbiol. 1986, 51, 1235–1238. [Google Scholar] [CrossRef] [PubMed]
- Abildgren, M.P.; Lund, F.; Thrane, U.; Elmholt, S. Czapek-Dox agar containing iprodione and dicloran as a selective medium for the isolation of Fusarium species. Lett. Appl. Microbiol. 1987, 5, 83–86. [Google Scholar] [CrossRef]
- Thrane, U.; Filtenborg, O.; Frisvad, J.C.; Lund, F. Improved methods for detection and identification of toxigenic Fusarium species. In Modern Methods in Food Mycology; Samson, R.A., Hocking, A.D., Pitt, J.I., King, A.D., Eds.; Elsevier: Amsterdam, The Netherlands, 1992; pp. 285–291. [Google Scholar]
- Alborch, L.; Bragulat, M.R.; Cabañes, F.J. Comparison of two selective culture media for the detection of Fusarium infection in conventional and transgenic maize kernels. Lett. Appl. Microbiol. 2010, 50, 270–275. [Google Scholar] [CrossRef] [PubMed]
- Castellá, G.; Bragulat, M.R.; Rubiales, M.V.; Cabañes, F.J. Malachite green agar, a new selective medium for Fusarium spp. Mycopathologia 1997, 137, 173–178. [Google Scholar] [CrossRef]
- Mielniczuk, E.; Skwaryło-Bednarz, B. Fusarium Head Blight, mycotoxins and strategies for their reduction. Agronomy 2020, 10, 509. [Google Scholar] [CrossRef]
- Palazzini, J.; Fumero, V.; Yerkovich, N.; Barros, G.; Cuniberti, M.; Chulze, S. Correlation between Fusarium graminearum and deoxynivalenol during the 2012/13 wheat Fusarium head blight outbreak in Argentina. Cereal Res. Commun. 2015, 43, 627–637. [Google Scholar] [CrossRef]
- Wilson, W.; Dahl, B.; Nganje, W. Economic costs of Fusarium Head Blight, scab and deoxynivalenol. World Mycotoxin J. 2018, 11, 291–302. [Google Scholar] [CrossRef]
- CAST. Mycotoxins: Risks in Plant, Animal, and Human Systems; Task Force Report No. 139; Council for Agricultural Science and Technology: Ames, IA, USA, 2003. [Google Scholar]
- Segalin, M.; Reis, E.M. Semi-selective medium for Fusarium graminearum detection in seed samples. Summa Phytopathol. 2010, 36, 338–341. [Google Scholar] [CrossRef]
- Thompson, R.S.; Aveling, T.A.S.; Prieto, R.B. A new semi-selective medium for Fusarium graminearum, F. proliferatum, F. subglutinans and F. verticillioides in maize seed. S. Afr. J. Bot. 2013, 84, 94–101. [Google Scholar] [CrossRef]
- Jung, B.; Lee, S.; Ha, J.; Park, J.-C.; Han, S.-S.; Hwang, I.; Lee, Y.-W.; Lee, J. Development of a selective medium for the fungal pathogen Fusarium graminearum using toxoflavin produced by the bacterial pathogen Burkholderia glumae. Plant Pathol. J. 2013, 29, 446. [Google Scholar] [CrossRef]
- Frąc, M.; Gryta, A.; Oszust, K.; Kotowicz, N. Fast and accurate microplate method (Biolog MT2) for detection of Fusarium fungicides resistance/sensitivity. Front. Microbiol. 2016, 7, 489. [Google Scholar] [CrossRef]
- Masiello, M.; Somma, S.; Ghionna, V.; Logrieco, A.F.; Moretti, A. In vitro and in field response of different fungicides against Aspergillus flavus and Fusarium species causing ear rot disease of maize. Toxins 2019, 11, 11. [Google Scholar] [CrossRef] [PubMed]
- Nicholson, P.; Simpson, D.R.; Weston, G.; Rezanoor, H.N.; Lees, A.K.; Parry, D.W.; Joyce, D. Detection and quantification of Fusarium culmorum and Fusarium graminearum in cereals using PCR assays. Physiol. Mol. Plant Pathol. 1998, 53, 17–37. [Google Scholar] [CrossRef]
- Hofgaard, I.S.; Seehusen, T.; Aamot, H.U.; Riley, H.; Razzaghian, J.; Le, V.H.; Hjelkrem, A.-G.R.; Dill-Macky, R.; Brodal, G. Inoculum potential of Fusarium spp. relates to tillage and straw management in Norwegian fields of spring oats. Front. Microbiol. 2016, 7, 556. [Google Scholar] [CrossRef]
- Ashiq, S.; Edwards, S.G.; Fatukasi, O.; Watson, A.; Back, M.A. In vitro activity of isothiocyanates against Fusarium graminearum. Plant Pathol. 2022, 71, 594–601. [Google Scholar] [CrossRef]
- Leslie, J.F.; Summerell, B.A. The Fusarium Laboratory Manual; Blackwell Publishing: Ames, IA, USA, 2006. [Google Scholar]
- Bragulat, M.R.; Martinez, E.; Castella, G.; Cabanes, F.J. Selective efficacy of culture media recommended for isolation and enumeration of Fusarium spp. J. Food Prot. 2004, 67, 207–211. [Google Scholar] [CrossRef]
- IARC (International Agency for Research on Cancer). Overall evaluations of carcinogenicity: An updating of IARC monographs volumes 1 to 42. IARC Monogr. Identif. Carcinog. Hazards Hum. 1987, 7, 1–440. [Google Scholar]
- US EPA-OPP, United States Environmental Protection Agency (Office of Pesticide Programs). Chemicals Evaluated for Carcinogenic Potential Annual Cancer Report 2018. 2018, pp. 1–40. Available online: https://apublica.org/wp-content/uploads/2020/05/chemicals-evaluated.pdf (accessed on 25 November 2021).
- Culp, S.J.; Mellick, P.W.; Trotter, R.W.; Greenlees, K.J.; Kodell, R.L.; Beland, F.A. Carcinogenicity of malachite green chloride and leucomalachite green in B6C3F1 mice and F344 rats. Food Chem. Toxicol. 2006, 44, 1204–1212. [Google Scholar] [CrossRef] [PubMed]
- Rao, K.V.; Fernandes, C.L. Progressive effects of malachite green at varying concentrations on the development of N-nitrosodiethylamine induced hepatic preneoplastic lesions in rats. Tumori 1996, 82, 280–286. [Google Scholar]
- IARC (International Agency for Research on Cancer). Gentian violet, leucogentian violet, malachite green, leucomalachite green, and CI Direct Blue 218. Monogr. Identif. Carcinog. Hazards Hum. 2022, 129, 1–178. [Google Scholar]
- Srivastava, S.; Sinha, R.; Roy, D. Toxicological effects of malachite green. Aquat. Toxicol. 2004, 66, 319–329. [Google Scholar] [CrossRef]
- Vujanovic, V.; Hamel, C.; Jabaji-Hare, S.; St-Arnaud, M. Development of a selective myclobutanil agar (MBA) medium for the isolation of Fusarium species from asparagus fields. Can. J. Microbiol. 2002, 48, 841–847. [Google Scholar] [CrossRef]
- Thrane, U. Comparison of three selective media for detecting Fusarium species in foods: A collaborative study. Intl. J. Food Microbiol. 1996, 29, 149–156. [Google Scholar] [CrossRef] [PubMed]

| Media | Diluent | Colony-Forming Units Plate−1 | |||||
|---|---|---|---|---|---|---|---|
| 104 | 103 | 102 | |||||
| Fg a | Other b | Fg | Other | Fg | Other | ||
| CZPD c | Sterile distilled water | 24 (3) d | 0 | 2 (1) | 0 | 1 (1) | 0 |
| Soil suspension | 28 (2) | 48 (2) | 7 (2) | 58 (7) | 3 (1) | 55 (5) | |
| fluxapyroxad-CZPD d | Sterile distilled water | 32 (4) | 0 | 3 (1) | 0 | 1 (1) | 0 |
| Soil suspension | 26 (2) | 49 (5) | 10 (2) | 61 (7) | 2 (1) | 70 (3) | |
Disclaimer/Publisher’s Note: The statements, opinions and data contained in all publications are solely those of the individual author(s) and contributor(s) and not of MDPI and/or the editor(s). MDPI and/or the editor(s) disclaim responsibility for any injury to people or property resulting from any ideas, methods, instructions or products referred to in the content. |
© 2023 by the authors. Licensee MDPI, Basel, Switzerland. This article is an open access article distributed under the terms and conditions of the Creative Commons Attribution (CC BY) license (https://creativecommons.org/licenses/by/4.0/).
Share and Cite
Ashiq, S.; Back, M.; Watson, A.; Edwards, S.G. Screening of Fungicides and Comparison of Selective Media for Isolation of Fusarium graminearum from Soil and Plant Material. Pathogens 2023, 12, 197. https://doi.org/10.3390/pathogens12020197
Ashiq S, Back M, Watson A, Edwards SG. Screening of Fungicides and Comparison of Selective Media for Isolation of Fusarium graminearum from Soil and Plant Material. Pathogens. 2023; 12(2):197. https://doi.org/10.3390/pathogens12020197
Chicago/Turabian StyleAshiq, Samina, Matthew Back, Andrew Watson, and Simon G. Edwards. 2023. "Screening of Fungicides and Comparison of Selective Media for Isolation of Fusarium graminearum from Soil and Plant Material" Pathogens 12, no. 2: 197. https://doi.org/10.3390/pathogens12020197
APA StyleAshiq, S., Back, M., Watson, A., & Edwards, S. G. (2023). Screening of Fungicides and Comparison of Selective Media for Isolation of Fusarium graminearum from Soil and Plant Material. Pathogens, 12(2), 197. https://doi.org/10.3390/pathogens12020197








